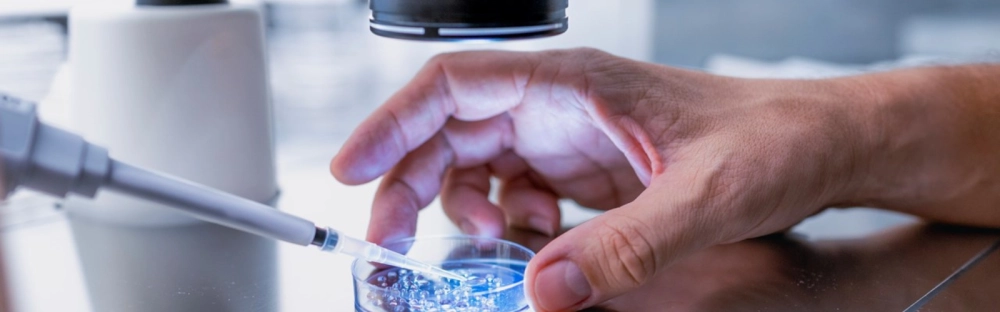
a85c449b6dda-Untitled-design-1-.png.webp

Latest news
Insights
Latest news
You will find here the latest news of Forvis Mazars in Luxembourg and in the world.
SFDR 2.0: A reset of the EU Sustainable Finance Disclosure Framework

On 20 November 2025, the European Commission published its SFDR 2.0 Proposal to amend the Sustainable Finance Disclosure Regulation (SFDR). The initiative aims to simplify disclosure requirements, improve coherence with other EU legislation, and enhance transparency for investors. Implementation is foreseen between 2027 and 2028, with further delegated act.
Digital transformation: from ambition to execution

How senior business leaders approach digital transformation technology is reshaping the future of performance, resilience and growth
Cyber security in 2026: navigating innovation, regulation and resilience

Cyber security faces a convergence of emerging technologies, evolving regulations and advanced threats. To prepare for what’s next, organisations will need to embrace strategic governance and intentional innovation.
Forvis Mazars appointed new auditor of the European Central Bank
C-suite barometer: manufacturing sector view

As global uncertainty reshapes the industrial landscape, manufacturers are under increasing pressure to adapt and compete. Yet many leaders remain confident in their growth ambitions. In this shifting environment, strategic agility is becoming a vital asset. Drawing on perspectives from executives in more than 35 countries, this report explores how manufacturing leaders are responding to change and where they are uncovering new opportunities for growth.
Beyond Compliance: Sharpening your EMIR Refit reporting under CSSF scrutiny

The European Market Infrastructure Regulation (EMIR) requires all derivative contracts to be reported to Trade Repositories (TRs), which act as central data hubs for maintaining comprehensive records of derivative activity across the EU.
C-suite barometer: technology, media and telecommunications sector view
What’s next for Forvis Mazars – press interview with our Chairman and CEO

The International Accounting Bulletin (IAB) speaks with Chairman Hervé Hélias and CEO Pascal Jauffret to find out what’s next for Forvis Mazars Group.
C-suite barometer: financial services sector view

In an increasingly complex and fast-paced environment, financial services leaders are focusing their efforts on strategic transformation, operational resilience and workforce readiness. Drawing on insights from executives across more than 35 countries, our latest report reveals how organisations in the sector are adapting to ongoing disruption, balancing risk with innovation and refining their long-term ambitions.
C-suite barometer: life sciences & pharmaceuticals sector view
In a year marked by global uncertainty, shifting regulations, and fast-moving innovation, leaders in the life sciences & pharmaceuticals sector are redefining their strategic priorities. Drawing on insights from executives from across more than 35 countries, our latest report captures how sector players are navigating complexity, investing in growth, and positioning themselves for long-term success in a competitive landscape.

